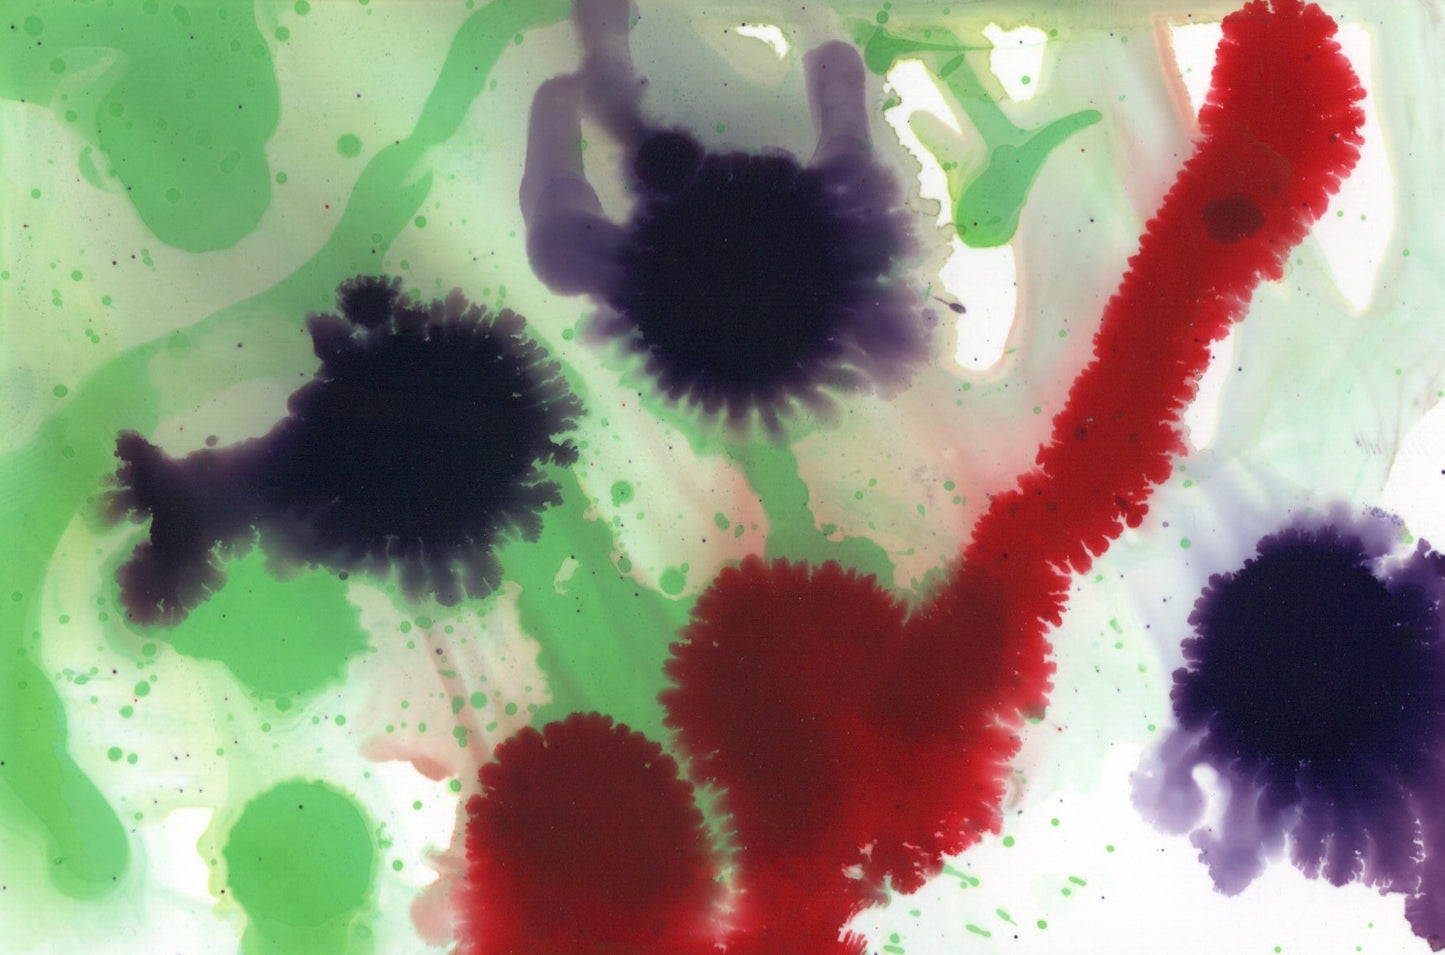
Abstract 5 Alcohol Ink Fuzzy Blobs

1
/
of
1
NateCreates
Abstract 5 Alcohol Ink Fuzzy Blobs
Abstract 5 Alcohol Ink Fuzzy Blobs
Regular price
$7.00 USD
Regular price
Sale price
$7.00 USD
Unit price
/
per
Couldn't load pickup availability
abstract
alcohol ink
4" x 6" original
purple, red, green
Share